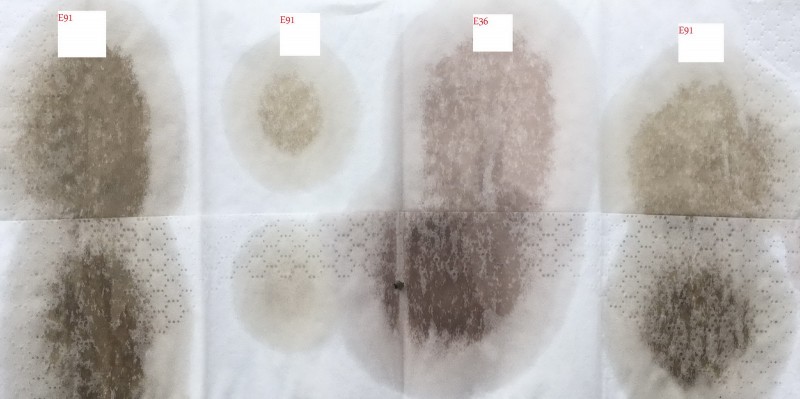
IMG_5151.jpg (256.21 KiB) 2191 zobrazení IMG_5151.jpg

Pondelok, 13. Marca 2017, 09:37
zdravim, chcel by som vymenit olej v serve (E91 330xd) ale neviem ci tam mam ATF alebo CHF11S. Na viecku mam sice napisane ATF only ale neviem ci na nom niekedy nebola zelena nalepka a pri umyvani motora nesla dole. Z nadrzky som vytiahol vzorku, vytiahol som aj z E36 (v tej je urcite AFT, ta sa menila cca pred 5 rokmi)
-
Prílohy
-